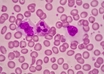

Decision to ban production & sale of oxytocin not instant: Centre tells HC
PTI | Sep 22, 2018
FDA approves new kind of treatment for hairy cell leukemia
FDA Press Announcements | Sep 21, 2018
Vitamin D may reduce cancer risk, breast cancer mortality
ANI | Sep 20, 2018
ERS 2018: TLD procedure reduces respiratory problems in COPD patients
ERS International Congress 2018 | Sep 19, 2018
37.7 lakh children to be vaccinated from Sept 23 to Oct 20 in J&K
UNI | Sep 19, 2018
Muscle relaxants may increase respiratory complications risk
IANS | Sep 19, 2018
No coercive action against sale of available banned FDC drugs: HC
IANS | Sep 19, 2018
Paracetamol use in infancy increases risk of asthma: ERS Congress 2018
ANI | Sep 18, 2018
Supreme Court withdraws ban on Saridon and two other banned drugs
Partner Content | Sep 18, 2018
Inhaled steroids may increase risk of lung infections
ANI | Sep 17, 2018
Most read this week